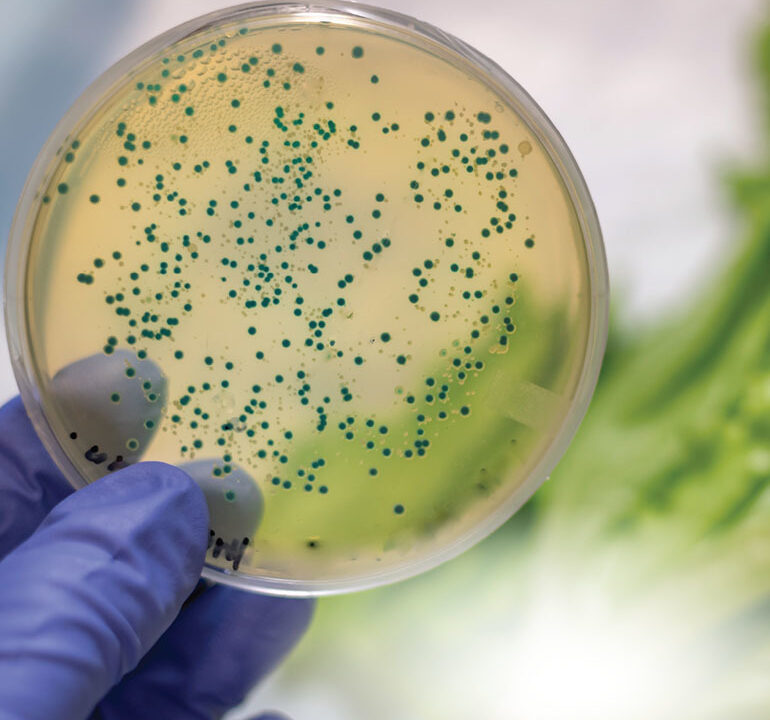

Afood recall is a stressful event for everyone involved. For the companies, it usually means a loss of profit and reputation. Regulators attempt to balance public safety and potentially conflicting interests of stakeholders. Consumers may struggle to determine if they own or have consumed contaminated food, and food service and nutrition managers are caught examining their inventory and records to determine if the food they are responsible for is involved in the recall. However, if everyone plays their part successfully, Canada’s recall system does a great job at keeping our food supply safe and reducing the size and scope of outbreaks when they do occur.
CANADA’S RECALL SYSTEM
Food recalls are somewhat common in Canada — there were 185 recalls in 2023 and, at the time of writing, there have been 72 so far in 2024. While these numbers sound extraordinarily high, it’s important to keep in mind that some recalls are much more serious than others. There are three classes of recalls. Class I recalls are the most serious and are defined by a high level of risk associated consuming the affected food that may result in serious illness or death. Class II recalls are associated with a moderate risk that may lead to short-term health issues, and Class III recalls are low to no risk. Class III recalls mostly involve foods that do not pose health risks, but where foods do not comply with legislation.
As an example, there is currently a Class I recall for Enoki Mushrooms in Ontario due to the presence of Listeria monocytogenes. Food contaminated with Listeria may look and smell fine, but the bacteria can cause a severe infection in children, the elderly, and pregnant women that is associated with a very high mortality rate. Most people will also remember the Canadawide Class I recall of Malichita and Rudy brand cantaloupe in late 2023 that was connected to a Salmonella outbreak that resulted in several deaths.
By comparison, there is currently a Class III recall on Morning Glory Muffins in Alberta due to the presence of undeclared egg. Eggs are, of course, a common, nutritious ingredient commonly used in many products in Canada. However, our legislation requires it be included in the ingredient list on the product if it is used. While this recall may seem unnecessary or even frivolous given the low risk of consuming eggs, it is important to consider the possible implications of improper labelling for those with severe egg allergies.
When a recall is issued, the company responsible for the product will contact all distributors and retailers that have received the recalled food, while the Canadian Food Inspection Agency (CFIA) is responsible for informing the public via its website (recallsrappels.canada.ca/en) and the media and providing guidance to industry to remove all of the recalled food from the marketplace.
THE ROLE OF FOOD SERVICE AND NUTRITION MANAGERS
Ultimately, managers who oversee the preparation, service, and sale of food are responsible to ensure that the food is safe for human consumption. The food they are responsible for and the establishment in which the food is prepared should meet all legislative requirements. During a recall, the most important thing is to ensure recalled food is not served, and clients who may have consumed recalled food are contacted.
The first step in effectively managing a recall is being well informed. Although you should be contacted if ingredients you purchased are involved in a recall, it’s a great idea to pay attention to the local news. The news is a great source of information on Class I recalls. In addition, it’s wise to scan the Government of Canada’s website once or twice a week and see if any ingredients you’ve purchased are being recalled (recalls-rappels.canada.ca/en). If you are aware of an ongoing recall that affects a product you commonly use, check the website daily. Even if your specific brand and/or lot number(s) are not currently affected, the scope of the recalls often change rapidly as the CFIA learns more in its investigation, and the recall may eventually expand to include your product.
If you find yourself in possession of recalled food items, make sure these items are not distributed to clients or used as ingredients in food products to be distributed to clients. Identify all the products that used or contacted the recalled item; they must now be destroyed. It’s important to establish and maintain a traceability system that will allow you to effectively navigate a recall, and there are software packages available to help with this. Separate recalled food items from other food to avoid cross-contamination. Communicate the recall to your staff, and clearly indicate that recalled food items should be found and destroyed. If recalled items are partially through your distribution network (in the process of being delivered to clients, or at a retail location), organize for these items to be recalled or destroyed on site.
If you have distributed or served food that included recalled items, prepare a distribution list that includes each client’s name and contact information. Prepare and send a notice to your clients that includes all the relevant information. The CFIA provides templates for these notices (inspection.canada.ca/en/food-safety-industry/recall-procedure#appa). If you are unable to notify everyone at once, prioritize clients who are, or who serve, vulnerable populations.
In certain instances, food service and nutrition managers could also be involved in triggering a recall. If you suspect that food your establishment prepared or served seems to have caused symptoms of an infection in your clients, this can and should be reported to the CFIA (inspection.canada.ca/en/food-safety-consumers/where-reportcomplaint). If an ingredient was the source of the infection, it’s likely that the outbreak extends beyond your establishment, and you could play an important role in rapidly identifying and stopping an outbreak.
It’s also a great idea to hold a recall simulation with your staff before an actual event occurs. This practice is tremendously valuable in allowing staff to practice what they would do in the event of a recall before the pressure is on, and it can allow managers to identify gaps in their processes or traceability systems.
THE RECALL SYSTEM
The recall system in Canada involves five steps that aim to lead to rapid, accurate, and consistent decisions.
Step 1 — The Trigger: The recall starts with a trigger. The trigger can take many forms including an outbreak or unusually high number of cases of a certain infection, a finding in routine CFIA testing or inspection, a consumer complaint, or a company-initiated recall often due to an identified issue in processing.
Step 2 — Food Safety Investigation: In this step, regulatory bodies define the scope of the investigation, they conduct trace-back and trace-forward activities, and they try to identify the cause of the problem. This step may involve Health Canada, the Canadian Food Inspection Agency, and the Public Health Agency of Canada.
Step 3 — Hazard Risk Assessments: Hazard Risk Assessments are conducted by Health Canada to identify the level of risk a specific food item presents to the Canadian population. Decisions about initiating a recall are made here.
Step 4 — The Recall: A class of recall is assigned, steps are taken to implement the recall, the public is informed, and CFIA monitors and audits the recall process.
Step 5 — Follow-up: The CFIA will work with the food company to resolve the issue that led to the recall.
LESSONS LEARNED
Being informed and prepared to deal with a recall are your most effective tools for managing them. Communication with suppliers, regulatory agencies, and clients is also essential in navigating a recall. Be prepared and then react calmly and decisively.
After a recall, it’s important to review how you and your team performed and improve your operating practices so future recalls can be handled even more efficiently.
Dr. Jennifer Ronholm is an associate professor of food microbiology and Canada research chair at McGill University. She earned a PhD in microbiology and immunology from the University of Ottawa and completed a post-doctoral training in the Bureau of Microbial Hazards at Health Canada. She teaches several courses on food microbiology at McGill University and her research program aims at understanding the interactions between foodborne pathogens and the microbiome.